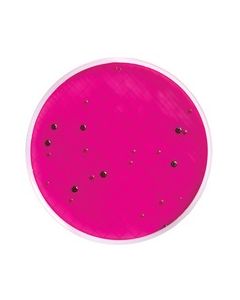
MHA000P2E.jpg

The store will not work correctly when cookies are disabled.
- Termos de pesquisa relacionados
-
millipore
-
filtracao polissulfona nalgene 47mm
-
filtracao polissulfon nalgene 47mm
-
filtracao polisulfon nalgene 47mm
-
filtracao polisulfona nalgene 47mm

KIT DE MANUTENÇÃO MANIFOLD EZ-FIT MILLIPORE - INCLUI LUBRIFICANTE E ESCOVA
Modelo: EZFITMAKIT
R$ 1.363,48

CARTAO ABSORVENTE TIPO AP10 (PAD) CELULOSE DIAM 47mm MILLIPORE - 100 UND
Modelo: AP1004700
R$ 485,37

MEIO M ENDO EM AMPOLA 2ml PARA COLIFORMES TOTAIS (CX) MILLIPORE
Modelo: MHA000P2E
R$ 1.066,44

PLACA 96 POÇOS EM PP FUNDO V NAO ESTERIL (100/ CX) MILLIPORE
Modelo: MSCPNPP00
R$ 2.565,17

MODULO PRE-TRATAMENTO PROGARD NP2 P/ MILLI-Q INTEGRAL MILLIPORE - SEM POLIFOSFATO
Modelo: PR0G0TNP2
R$ 4.266,37

CARTUCHO QUANTUM ICP P/ MILLI-Q ELEMENT MILLIPORE - P/ SISTEMA ULTRAPURIFICAÇÃO ESPECIAL
Modelo: QTUM00ICP
R$ 4.299,62

MODULO SIMPLIPAK3 P/ SIMPLICITY MILLIPORE - ALIMENTADO C/ AGUA DEIONIZADA, CONTENDO ALTA SEDIMENTAÇÃO
Modelo: SIPK0SIX3
R$ 2.830,80

MODULO SmartPak® RO 8 PACK PRE-TRATAMENTO E OSMOSE REVERSA MILLIPORE
Modelo: SPR08S001
R$ 2.568,02

MANIFOLD 6 POSICOES, EZ-FIT MILLIPORE - P/ TULIPA DE TAMPA DE BORRACHA
Modelo: EZFITH0LD6
R$ 36.035,00

CILINDRO DE EXTENSAO PARA COPOS MANIFOLD DE 25 mm MILLIPORE - 12 UND
Modelo: XX2702555
R$ 2.485,79

SUPORTE PARA SERINGA DIAM. 25 mm EM AÇO INOX FEMEA NPTF MILLIPORE
Modelo: XX3002514
R$ 3.291,54

MEMB. FILTRANTE PTFE OMNIPORE DIAM. 47mm PORO 0,10um MILLIPORE (CX/100 UND)
Modelo: JVWP04700
R$ 1.336,35